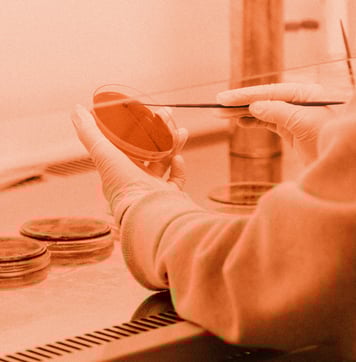

SCRUM
SCRUM

The dynamic trio of Scrum roles - Scrum Master, Product Owner, and the Development Team - act as the pillars of this agile framework. Each role brings unique responsibilities, creating a collaborative dance that propels the project forward.
Start Sprint:
Initiates a new sprint cycle
Sprint Planning:
Involves the Scrum Master, Product Owner, and Development Team. The team collaboratively plans the work to be done during the sprint, defining the Sprint Goal and creating the Sprint Backlog.
Daily Scrum:
Daily stand-up meetings involving the Scrum Master and the Development Team. Each team member provides updates on their progress, discusses challenges, and plans for the next 24 hours.
Sprint Execution:
The Development Team works on the items from the Sprint Backlog.
Sprint Review:
Involves the Scrum Master, Product Owner, and Development Team. The team presents the completed work to stakeholders, and feedback is gathered for future improvements.
Sprint Retrospective:
A reflection session involving the Scrum Master and the Development Team. The team discusses what went well, what could be improved, and actions to enhance future sprints.
End Sprint:
Marks the completion of the sprint cycle, and the process begins again with a new Sprint Planning.
Roles:
Scrum Master:
Facilitates the Scrum events, ensures the team adheres to Scrum principles, and removes impediments.
Product Owner:
Represents the stakeholders, prioritizes the Product Backlog, and defines the Sprint Goal.
Development Team:
Responsible for delivering increments of potentially releasable product functionality.
Scrum principles are the guiding lights that illuminate the agile path. From prioritizing customer satisfaction to embracing change, these principles underpin the agile mindset that propels teams towards continuous improvement.

